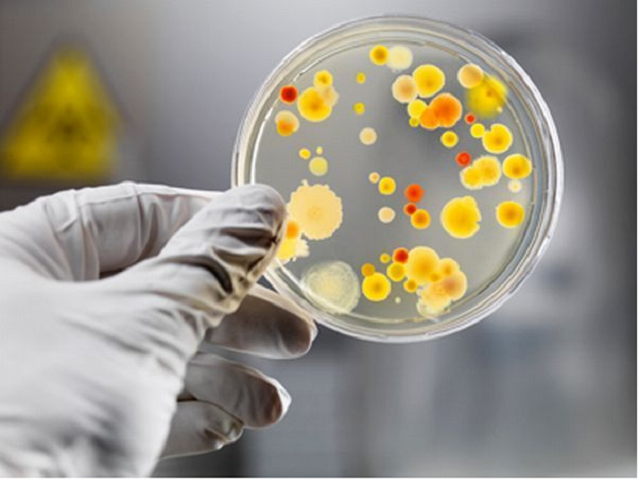
Вспышка сальмонеллеза: врач назвал самый опасный продукт

Вспышка сальмонеллеза: врач назвал самый опасный продукт
Вспышка сальмонеллеза: врач назвал самый опасный продукт
В текущем сезоне в Украине участились случаи сальмонеллеза; потенциальную опасность могут представлять несвежие молочные продукты, мясо, вяленая рыба и другие продукты и блюда, хранившиеся или приготовленные в ненадлежащих условиях.
Об этом рассказала участковый врач Рита Гофман.
"В этом году очень много сальмонеллеза. Многие случаи отравлений связаны с тем, что продукты покупают на стихийных рынках, в кафе, забегаловках и прочих неподходящих для этого местах. Опасным может быть просроченное молоко, просроченное мясо, рыба, в частности, вяленая - в этом году наблюдается вспышка сальмонеллеза от вяленой рыбы", - сообщила она.
Чтобы избежать заболевания, врач порекомендовала "быть очень аккуратными" в выборе продуктов питания, особенно тех, которые потенциально могут быть заражены сальмонеллой, "не есть что попало" и покупать продукты и блюда только в проверенных местах.
В этом контексте Рита Гофман напомнила о том, что в Украине "под медицинскую реформу закрыли санэпидстанции". "С одной стороны, прекратились сумасшедшие взятки и террор со стороны СЭС, но с другой – пропал серьезный контроль. Кто-то ведь должен контролировать качество", - посетовала она.
Теги: испорченные продуктысальмонеллезБолезниВрачи

Коментарі:
comments powered by DisqusЗагрузка...
Наші опитування
Показати результати опитування
Показати всі опитування на сайті











